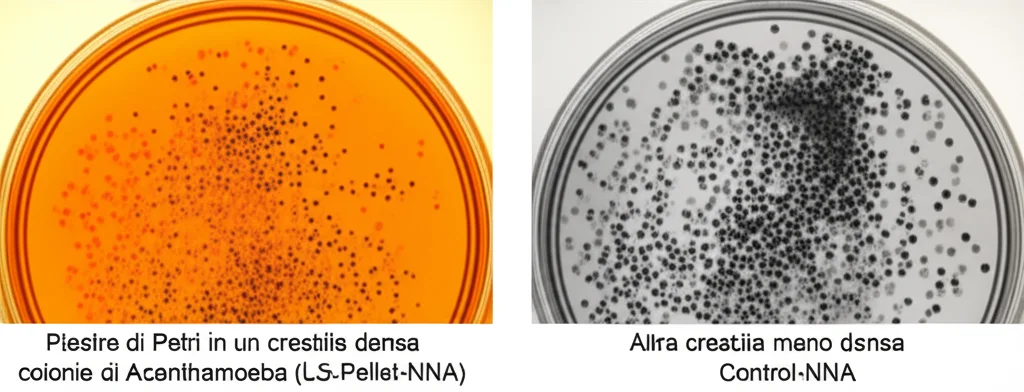
Piastre di Petri in un laboratorio di microbiologia, una mostra una crescita densa di colonie di Acanthamoeba (LS-Pellet-NNA) e un'altra una crescita meno densa (Control-NNA). Illuminazione da laboratorio, obiettivo macro 60mm, focus selettivo sulla piastra con crescita densa.

Amoebe Sotto Steroidi: Nanotecnologie e Saliva di Sanguisuga per Coltivarle in un Lampo!
Amici scienziati e curiosi, oggi vi porto con me in un viaggio affascinante nel mondo microscopico, un mondo popolato da creature tanto piccole quanto potenzialmente insidiose: le Acanthamoeba spp. Se non ne avete mai sentito parlare, beh, preparatevi, perché queste amebe sono più comuni di quanto pensiate!
Chi sono le Acanthamoeba e perché dovremmo preoccuparci?
Immaginate dei microscopici organismi unicellulari, dei veri e propri protozoi, che se ne vanno a spasso nell’ambiente: le trovate nel suolo, nelle fonti d’acqua, persino nella polvere di casa. Fin qui, potreste pensare ” эм, e allora?”. Il problema è che queste piccole canaglie sono parassiti opportunisti e possono causare infezioni piuttosto serie. La più nota è la cheratite da Acanthamoeba, un’infiammazione della cornea che può portare a conseguenze visive gravi, soprattutto nei portatori di lenti a contatto. Ma non finisce qui: possono anche causare l’encefalite amebica granulomatosa, una patologia neurologica decisamente preoccupante. E, come se non bastasse, studi epidemiologici recenti ci dicono che i casi di cheratite da Acanthamoeba sono in aumento. Un campanello d’allarme che non possiamo ignorare!
Le terapie attuali? Funzionano bene solo se si interviene prestissimo, ma se l’infezione è già in stadio avanzato, l’efficacia cala drasticamente. Capite bene che c’è un bisogno urgente di approcci terapeutici e, soprattutto, di metodi di coltivazione più efficaci per studiarle meglio e più in fretta.
La sfida della coltivazione in laboratorio
Coltivare le Acanthamoeba spp. in laboratorio è tradizionalmente un’impresa. Si usano colture axeniche (dove l’ameba cresce da sola) o monoxeniche (dove cresce insieme a un altro microrganismo, di solito batteri di cui si nutre). Entrambi i metodi, però, hanno i loro bei grattacapi:
- Perdita di virulenza dell’ameba dopo un po’ di tempo in coltura.
- Ridotta capacità di incistarsi (formare la cisti, la sua forma di resistenza).
- Possibili errori nell’inoculazione dei batteri nelle colture monoxeniche.
- Procedure lunghe e laboriose.
Insomma, non proprio una passeggiata. E se la coltivazione è difficile, anche la diagnosi si complica, perché i sintomi della cheratite da Acanthamoeba possono assomigliare a quelli di altre cheratiti, come quelle fungine o virali. Un ritardo nella diagnosi significa un ritardo nel trattamento giusto, e questo non va bene.
Nanotecnologie e Saliva di Sanguisuga: l’accoppiata vincente?
Ed è qui che entriamo in gioco noi, con un’idea un po’ fuori dagli schemi, ma che si è rivelata promettente! Abbiamo pensato: perché non sfruttare le meraviglie della nanotecnologia e le proprietà sorprendenti della saliva di sanguisuga?
La nanotecnologia, amici, sta aprendo porte incredibili in medicina, permettendo di sviluppare nuovi farmaci, sistemi diagnostici e terapie innovative. Noi abbiamo sviluppato dei nanocompositi magnetici rivestiti di acido umico. Cosa fanno di speciale? Beh, queste nanoparticelle hanno la fantastica capacità di aderire alla parete delle cisti di Acanthamoeba spp. senza danneggiarle. Immaginatele come delle minuscole calamite super-adesive che “acchiappano” le cisti. I nostri esperimenti hanno mostrato che questi nanocompositi si legano con grande affinità alle macromolecole sulla parete della cisti, facilitando l’aggregazione dei parassiti in un “pellet”, una sorta di concentrato.

Ma non ci siamo fermati qui. Per dare una bella spinta alla crescita delle amebe, abbiamo aggiunto al terreno di coltura (un agar non nutritivo, o NNA) la saliva di sanguisuga. Sì, avete capito bene, la saliva di quelle che un tempo si usavano per i salassi! La saliva di sanguisuga medicinale (Hirudo verbana, nel nostro caso) è un vero e proprio tesoro biologico: contiene oltre 100 proteine, peptidi e vari microrganismi (come Aeromonas hydrophila). È una fonte ricchissima di materia organica e molecole bioattive che promuovono la divisione cellulare, come l’enzima ialuronidasi, che aiuta a degradare la matrice extracellulare, favorendo motilità e divisione.
L’esperimento: come abbiamo fatto?
Vi spiego brevemente il nostro protocollo. Abbiamo raccolto campioni di acqua e suolo dal Lago Hılla in Turchia, li abbiamo processati per ottenere una sorta di “resina” contenente, sperabilmente, le nostre amebe.
Abbiamo diviso questa resina in due: un tubo di controllo e un tubo sperimentale.
- Dal tubo di controllo, abbiamo prelevato un po’ di resina e l’abbiamo inoculata direttamente su una piastra di NNA (Control-NNA).
- Nel tubo sperimentale, abbiamo aggiunto i nostri nanocompositi magnetici rivestiti di acido umico (MNPs@HA). Dopo aver agitato per bene per far interagire nanocompositi e amebe, abbiamo usato un magnete per separare il pellet (dove si concentravano le amebe “catturate”) dal surnatante (il liquido rimanente).
A questo punto, abbiamo fatto altre inoculazioni:
- Il surnatante su una piastra (Supernatant-NNA).
- Il pellet su due piastre diverse: una senza ulteriori aggiunte (Pellet-NNA) e una a cui abbiamo aggiunto 100 µL di saliva di sanguisuga (LS-Pellet-NNA).
Abbiamo incubato tutte le piastre a temperatura ambiente e monitorato la crescita ogni giorno per cinque giorni.
Risultati che fanno ben sperare!
Ebbene, i risultati sono stati entusiasmanti!
Già dopo 24 ore, abbiamo osservato crescita esclusivamente nel terreno LS-Pellet-NNA (quello con nanocompositi + saliva di sanguisuga). Un vero sprint!
Dopo 72 ore, la crescita è comparsa anche nei terreni Pellet-NNA (nanocompositi da soli) e Control-NNA (il controllo classico). Ma c’era una differenza notevole: i parassiti nel LS-Pellet-NNA erano molto più numerosi, anche se un po’ più piccoli, rispetto agli altri due terreni. Inoltre, la densità di crescita nel Pellet-NNA era superiore a quella del Control-NNA. Questo ci dice che già i soli nanocompositi aiutano a concentrare le amebe e a ottenere una coltura più ricca.
Alla fine delle 120 ore (5 giorni), nel terreno Supernatant-NNA non c’era traccia di crescita, confermando che i nostri nanocompositi avevano fatto un ottimo lavoro nel “ripulire” il campione e concentrare le amebe nel pellet. La crescita massima, in termini di densità, l’abbiamo vista proprio nel LS-Pellet-NNA.

La questione delle dimensioni ridotte dei trofozoiti (la forma attiva e mobile dell’ameba) nel terreno con saliva di sanguisuga è interessante. Una rapida proliferazione cellulare, come quella indotta dalla saliva, potrebbe influenzare la crescita e la maturazione, portando a queste variazioni morfologiche. È come se le amebe fossero così impegnate a dividersi da non avere “tempo” per crescere completamente. Altri studi suggeriscono che l’ambiente di coltura e la densità cellulare possono influenzare la morfologia delle amebe. È un aspetto che merita ulteriori indagini!
Perché questo metodo è una svolta?
Il nostro approccio combinato offre diversi vantaggi rispetto ai metodi convenzionali:
- Risparmio di tempo: crescita visibile in 24 ore contro le 72 ore o più dei metodi standard.
- Efficienza: maggiore densità di parassiti grazie alla concentrazione con nanocompositi e alla stimolazione della crescita con la saliva.
- Costo-efficacia: potenzialmente più economico rispetto a terreni complessi e procedure lunghe.
- Supporto biologico: la saliva di sanguisuga fornisce un ambiente ricco e stimolante.
Pensate alle implicazioni: poter coltivare rapidamente e in modo efficiente le Acanthamoeba spp. è cruciale per migliorare la diagnosi della cheratite, per testare nuovi farmaci e per condurre ricerche epidemiologiche più accurate.
Il nostro studio è, a quanto ne sappiamo, il primo a esplorare l’uso integrato di nanocompositi magnetici rivestiti di acido umico e saliva di sanguisuga per la coltivazione di questi parassiti. Un piccolo passo per noi, ma potenzialmente un grande passo per la lotta contro le infezioni da Acanthamoeba!

Cosa ci riserva il futuro?
Certo, come ogni studio scientifico che si rispetti, anche il nostro ha delle limitazioni. Per ora, abbiamo lavorato con isolati ambientali; il prossimo passo sarà validare il metodo con campioni clinici. Inoltre, non abbiamo ancora esplorato a fondo i meccanismi molecolari dietro l’azione dei nanocompositi e della saliva, né abbiamo condotto analisi tossicologiche per un’eventuale applicazione in vivo. Le variazioni morfologiche osservate sono state descrittive e necessitano di chiarimenti meccanicistici.
Ma la strada è tracciata! Studi futuri mireranno a ottimizzare questo metodo, a valutarne l’applicabilità su vasta scala e a investigare la sua accuratezza e riproducibilità nelle applicazioni cliniche.
La scienza è un processo continuo di scoperta e miglioramento, e noi siamo entusiasti di aver contribuito con un piccolo, ma speriamo significativo, tassello. L’uso sinergico di nanotecnologie e additivi biologici come la saliva di sanguisuga sembra davvero una strada promettente per affrontare sfide complesse come la coltivazione rapida di parassiti difficili. E chissà quali altre sorprese ci riserverà la natura, se solo impariamo a osservarla con occhi nuovi e un pizzico di creatività!
Fonte: Springer
